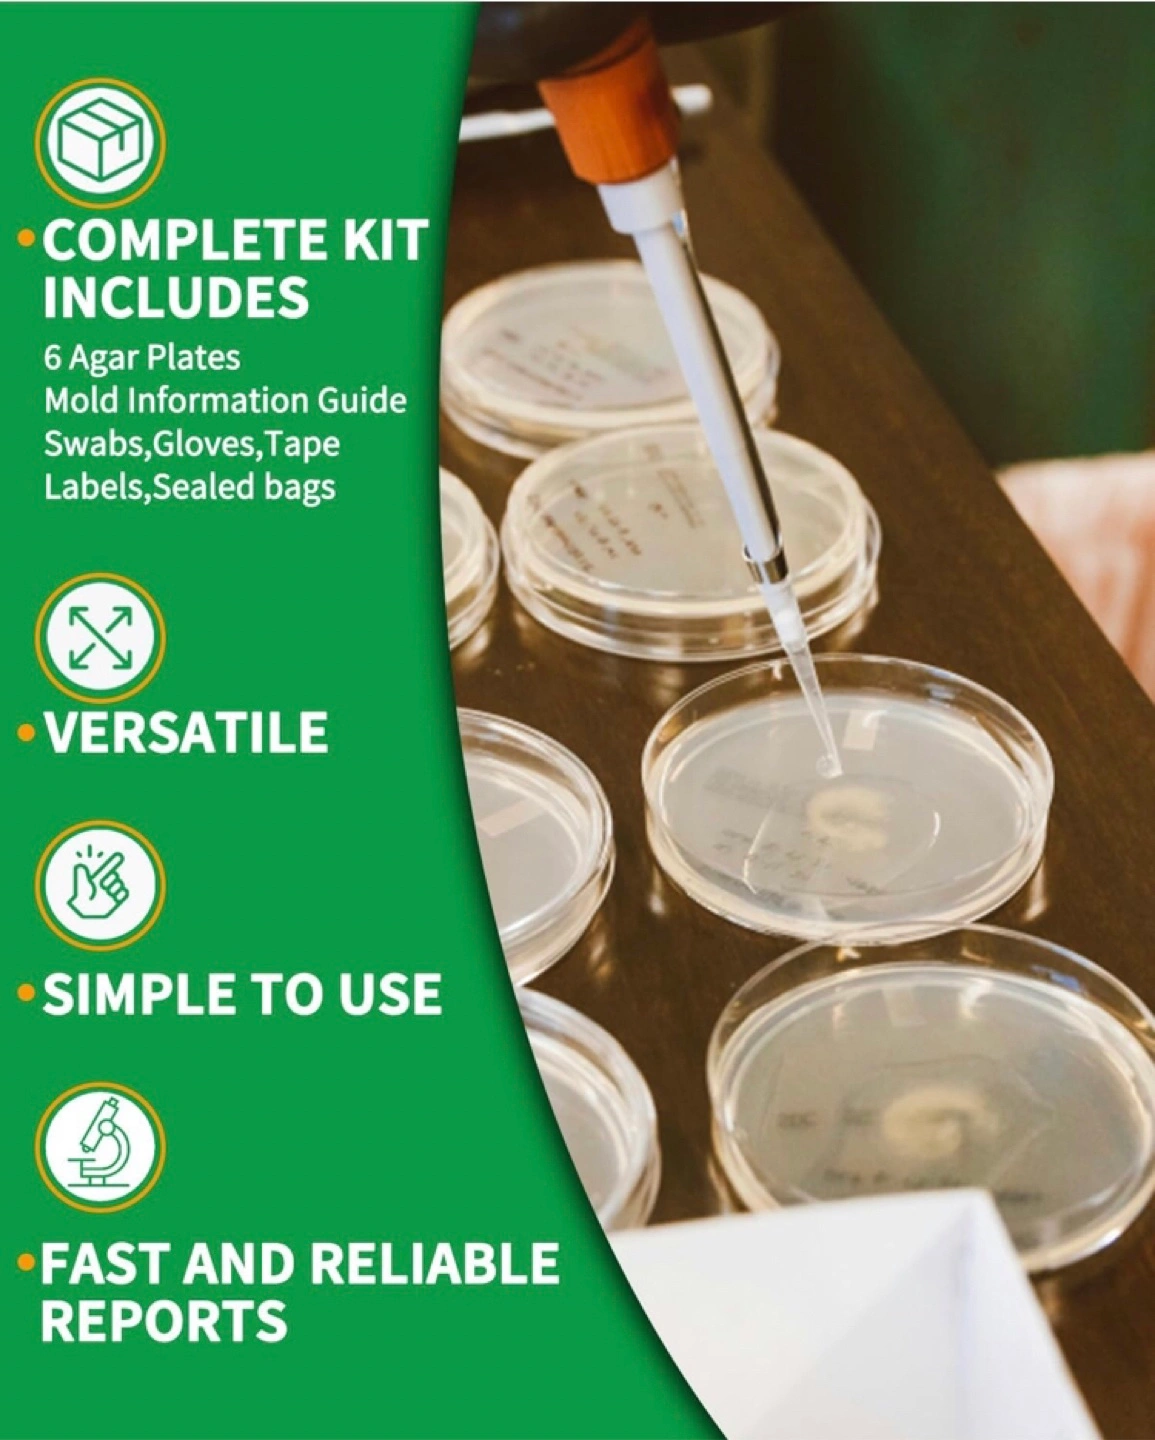

1 / 7
1 / 7
DIY Mold Test Kit
$8
This CIYERF Mold Test Kit is an easy DIY solution for testing air quality in your home or workplace. It includes everything you need: 6 agar plates, a mold information guide, swabs, gloves, labels, and sealed bags. It's versatile, simple to use, and provides fast and reliable reports
- ConditionNew
WHERE TO MEET
SELLER

SJean
Stouffville
1278 reviews
0 chats0 favorites9 views





